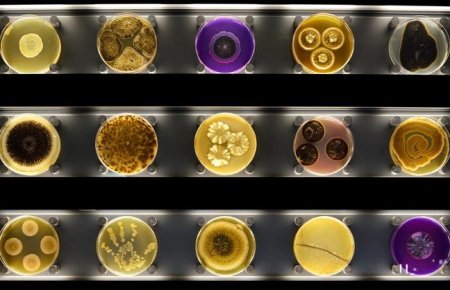

События и Мероприятия
Музейный май
Я переезжаю из Амстердама, а сходила только в два музея по музейной карте тут. Не порядок, пока все бесплатно и я рядом, надо использовать)
Критерий завершения
Ходить каждую неделю 1-2 раза в музей
Личные ресурсы
Музейная карта
Экологичность цели
Повысить качество отдыха
-
Stedelijk Museum Amsterdam
В Городском музее представлены все известные направления современного искусства.
![]()
-
ARTIS - Groote museum
![]()
-
ARTIS - Micropia
![]()
-
De Oude Kerk
![]()
-
De Nieuwe Kerk
![]()
-
Fashion for Good Museum
![]()
-
Museum Rembrandthuis
![]()
-
The Willet-Holthuysen House
![]()
- 1274
- 30 апреля 2024, 17:57
Не пропустите новые записи!
Подпишитесь на цель и следите за ее достижением